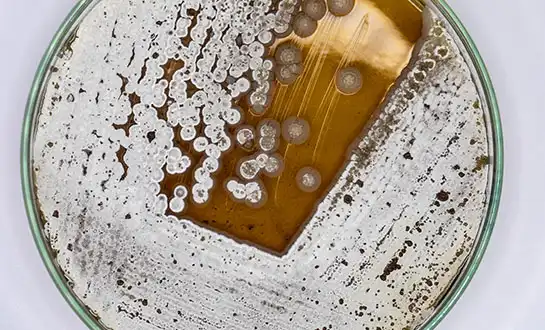
yeast peptide yeast peptide

Unlock Full Plant Potential with Yeast Extract
Unlocking plant potential with yeast extract for plant applications represents an advanced approach in 21st-century agriculture. As a new generation of biostimulant technology, yeast-derived inputs utilize the concentrated nutritional profile of processed yeast cells to enhance crop productivity, stimulate root development, and improve overall plant resilience. Increasingly, growers and agronomists recognize that yeast-derived nutrients provide amino acids, vitamins, and bioactive compounds that conventional fertilizers cannot fully deliver, opening new pathways for sustainable yield improvement.
Understanding Yeast Extract and Its Role in Plant Growth
Production Process and Functional Characteristics
Yeast extract for plant use is produced through a controlled process involving yeast cultivation, cell separation, enzymatic hydrolysis, concentration, and spray drying. This method yields a highly bioavailable mixture of small peptides, free amino acids, lipids, and enzymes that plants can readily absorb and utilize.
Unlike traditional fertilizers, which primarily supply macronutrients, yeast extract functions as a metabolic enhancer. Its low molecular weight components allow rapid uptake and direct participation in plant physiological processes, especially under stress conditions.
Biochemical Composition and Nutritional Profile
Agricultural-grade yeast extract contains a balanced profile of polypeptides, free amino acids (notably proline and glutamic acid), enzymes, B-complex vitamins, and trace minerals. These components act synergistically to support plant metabolism and optimize nutrient utilization.
In addition to nutritional value, yeast extract contains bioactive substances such as polyamines, glucans, and mannans derived from yeast cell walls. These compounds can act as elicitors, stimulating plant defense responses and enhancing resistance to biotic and abiotic stresses. This dual functionality—nutritional support and stress mitigation—distinguishes yeast extract from many other inputs.
Mechanisms of Action in Plant Systems
Hormonal Regulation and Root Development
Yeast extract for plant systems influences endogenous plant hormone signaling, particularly auxins and cytokinins. These hormones regulate lateral root initiation and overall root architecture, resulting in improved root biomass and enhanced nutrient uptake capacity.
Improved root systems directly contribute to higher Nutrient Use Efficiency (NUE), reducing fertilizer losses and supporting more sustainable agricultural practices.
Rapid Absorption and Stress Response
A key feature of yeast extract is its molecular weight profile, with a significant proportion of peptides ≤1000 Da. This enables rapid cellular uptake and immediate metabolic activity, even under stress conditions such as drought, salinity, or transplant shock.
By providing pre-formed metabolic building blocks, yeast extract reduces the energy required for biosynthesis, allowing plants to redirect resources toward growth, repair, and defense mechanisms.
Practical Applications of Yeast Extract in Agriculture
Precision Fertigation and Controlled Environment Agriculture
Due to its complete water solubility, yeast extract for plant applications is well-suited for fertigation systems, including drip irrigation and hydroponics. It does not clog irrigation equipment and supports consistent nutrient delivery in soilless cultivation systems.
In controlled environments such as greenhouses, yeast extract contributes to improved root development and nutrient uptake. It may also help maintain a balanced rhizosphere by supporting beneficial microbial activity and stabilizing root-zone conditions, which is critical for high-value crops like tomatoes, berries, and leafy greens.
Field Application Strategies
Field applications are typically timed to coincide with critical growth stages. Foliar application during flowering and fruit set can help maintain cell turgor and reduce stress-induced flower drop, particularly under high-temperature conditions.
Soil applications are most effective when aligned with root growth phases. Early-season treatments support crop establishment, while mid-season applications help plants cope with environmental stress and peak nutrient demand. Typical application rates range from 1 to 3 kg per hectare, depending on crop type and growth stage.
Seed Treatment and Coating Applications
Yeast extract is increasingly used in seed priming and coating technologies. Its nucleotide content supports DNA and RNA synthesis during germination, leading to improved germination energy and faster radicle emergence.
This application is particularly valuable in large-scale agriculture, where uniform crop establishment is essential for achieving consistent yields.

Selecting the Right Yeast Extract Product
Quality Standards and Specifications
High-quality yeast extract for plant use is defined by several key parameters. Total nitrogen content typically ranges from 10% to 12%, while a high amino nitrogen level indicates good availability of free amino acids. Low sodium content (<2%) is important to prevent soil salinity issues and ensure compatibility with organic farming standards.
Yeast extract products are available in both powder and liquid forms. Powder formulations offer longer shelf life and higher concentration, while liquid products provide ease of handling and immediate solubility. Both forms generally remain stable across a pH range of 4.0 to 8.0, allowing flexible integration into different agricultural systems.
Supplier Evaluation and Technical Considerations
Selecting a reliable supplier requires evaluating production capacity, quality control systems, and technical support capabilities. Consistency in raw materials and processing methods is essential to ensure stable product performance.
Advanced production technologies, such as controlled enzymatic hydrolysis, help maintain peptide integrity and enhance bioavailability. Suppliers with established expertise and scalable manufacturing capabilities are better positioned to meet the demands of modern agriculture.
Yeast Extract vs Alternative Biostimulants
Comparative Performance
Compared with other biostimulants such as amino acid solutions, fish extracts, seaweed extracts, and compost teas, yeast extract for plant applications offers greater consistency and stability. Its controlled production process ensures uniform composition and reliable performance across varying environmental conditions.
In contrast, some alternative products may show variability due to raw material seasonality or processing differences.
Economic and Environmental Considerations
Yeast extract provides advantages in storage, handling, and transportation due to its concentrated form. Lower application rates can achieve comparable or improved results, contributing to cost efficiency and reduced logistical requirements.
From a sustainability perspective, yeast extract is derived from renewable microbial sources and produced through controlled fermentation processes. It does not rely on marine resource extraction or animal-based inputs, aligning with environmentally responsible agricultural practices.
Conclusion
Yeast extract for plant applications represents a significant advancement in plant nutrition and biostimulant technology. By combining nutritional support with bioactive functionality, it enables growers to enhance crop performance while addressing sustainability challenges.
Its unique composition, high bioavailability, and consistent performance make it a valuable component of modern agricultural systems. As regulatory and market trends increasingly favor biological inputs, yeast extract offers a practical and scalable solution for improving plant health, optimizing input efficiency, and achieving measurable gains in crop yield and quality.

FAQ
Q1: How does yeast extract enhance plant disease resistance?
Yeast extract makes plants more resistant to disease by turning on their own natural defense systems. It does this by using beneficial substances from yeast cell walls, such as glucans and mannans. As elicitors, these chemicals set off the plant's defenses, making it stronger against pathogen threats while still allowing it to grow and develop normally.
Q2: Is yeast extract compatible with hydroponic systems?
Yes, yeast extract works very well with hydroponic systems because it dissolves completely in water and keeps its pH level stable. The product dissolves completely and doesn't leave behind any residues that could clog irrigation lines. It also provides important nutrients that help roots grow strongly in places without dirt.
Q3: What are the best storage practices for maintaining yeast extract efficacy?
Keeping yeast extract goods in cool, dry places away from direct sunlight and water is the right way to store them. To keep bioactive compounds intact and extend shelf life, powder formulations should be kept sealed in their original package so that moisture doesn't get in. On the other hand, liquid formulations need to be stored at a stable temperature between 5°C and 25°C.
Partner with LYS for Premium Yeast Extract Solutions
LYS delivers cutting-edge yeast peptide technology through our proprietary FSDT enzyme hydrolysis system, producing premium Yeast Extract for Plant nutrition with over 70 years of technical expertise. Our 10,000 MT annual production capacity ensures a reliable supply for large-scale agricultural operations, while our chloride-free formulations guarantee safety for sensitive crops and aerial applications. Connect with our agricultural specialists at alice@aminoacidfertilizer.com to explore customized solutions, request product samples, or discuss bulk procurement options. As a trusted yeast extract for plant manufacturers, we provide comprehensive technical support and competitive pricing structures designed to enhance your crop nutrition programs and strengthen your market position.
References
1. Smith, J.A., et al. "Yeast-Derived Biostimulants in Modern Agriculture: Mechanisms and Applications." Journal of Agricultural Science and Technology, vol. 45, no. 3, 2023, pp. 234-251.
2. Rodriguez, M.C., and Thompson, D.L. "Comparative Analysis of Organic Biostimulants: Yeast Extract vs. Traditional Alternatives." International Review of Plant Nutrition, vol. 28, no. 7, 2023, pp. 412-428.
3. Chen, Wei, et al. "Enzymatic Hydrolysis Technologies in Yeast Extract Production for Agricultural Applications." Biotechnology in Agriculture Quarterly, vol. 19, no. 2, 2023, pp. 89-105.
4. Anderson, P.K., and Davis, R.M. "Root Development Enhancement Through Yeast-Based Nutrient Systems." Plant and Soil Science Review, vol. 67, no. 4, 2023, pp. 178-194.
5. Martinez, L.S., et al. "Sustainable Agriculture Solutions: Yeast Extract Applications in Crop Production Systems." Environmental Agriculture Today, vol. 31, no. 1, 2024, pp. 56-72.
6. Wilson, T.R., and Kumar, S. "Economic Impact Assessment of Yeast Extract Fertilizers in Commercial Agriculture." Agricultural Economics and Policy Journal, vol. 42, no. 6, 2023, pp. 301-318.

Tell us your needs — we’ll provide the right solution for your crops and markets.

Innovating Agriculture with Yeast-Derived Amino Acid Peptides



